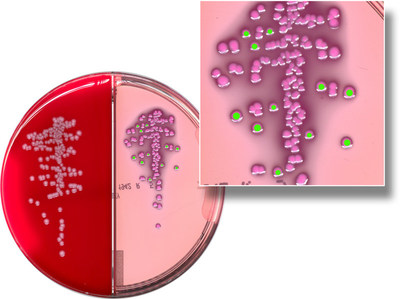
images

Press Releases

Deloitte Expands Managed Security Services and Solutions Suite For Cyber Threat Detection and Response
Jan 19, 2022
NEW YORK, Jan. 19, 2022 /PRNewswire/ -- Deloitte has expanded upon existing capabilities to launch Managed Extended Detection and Response (MXDR) by Deloitte. The suite of offerings…
Read MoreMitratech Acquires Spend Management Leader, Quovant
Jan 19, 2022
AUSTIN, Texas, Jan. 19, 2022 /PRNewswire/ -- Mitratech, the leading provider of legal and compliance software, is pleased to announce that it has acquired Quovant,…
Read More
Too early to bottom-fish in China’s property bonds, Greifenberg Digital says
Jan 19, 2022
NEW YORK, Jan. 19, 2022 /PRNewswire/ -- Greifenberg Digital, a member of the IMTE Group, commented today on the risks to Chinese property bonds as gauged by…
Read More
Spaulding Ridge Strengthens Cloud Advisory Practice; Welcomes Cloud Executives Ron Dimon and Rick Cadman to Build and Lead
Jan 19, 2022
CHICAGO, Jan. 19, 2022 /PRNewswire/ -- Spaulding Ridge, global cloud advisory and implementation firm, announced today that it's expanding its cloud advisory practice with the additions…
Read More
NetBase Quid and Twitter Get Up Close with Personal Care Products
Jan 19, 2022
SANTA CLARA, Calif., Jan. 19, 2022 /PRNewswire/ -- NetBase Quid, a global leader in AI-powered consumer and market intelligence, in partnership with Twitter, announced the results…
Read More
COPAN Diagnostics Announces Another Giant Step in the Evolution of Artificial Intelligence in Clinical Microbiology
Jan 19, 2022
MURRIETA, Calif., Jan. 19, 2022 /PRNewswire/ -- On the heels of recent news of FDA clearance for Colibri™, automated colony picking instrument for identification and antimicrobial…
Read More
New Ricoh solution helps insurance providers resolve claims faster to improve customer satisfaction
Jan 19, 2022
EXTON, Pa., Jan. 19, 2022 /PRNewswire/ -- Ricoh USA, Inc. today announced RICOH Claims Management Services, a purpose-built integrated service that solves a top challenge for insurance providers:…
Read MoreField Pros Direct is pleased to welcome Hunter Moss as he assumes the role of President and COO
Jan 19, 2022
ATLANTA, Jan. 19, 2022 /PRNewswire/ -- Field Pros Direct (FPD), an industry-leading, tech-enabled claims solution developed to simplify the claims process announced the appointment of Hunter…
Read MoreMitchell and asTech® Introduce Integrated Solution for OEM Scanning
Jan 19, 2022
SAN DIEGO and PLANO, Texas, Jan. 19, 2022 /PRNewswire/ -- Mitchell, an Enlyte company and leading technology and information provider for the Property & Casualty (P&C)…
Read MoreCynerio Research Finds Critical Medical Device Risks Continue to Threaten Hospital Security and Patient Safety
Jan 19, 2022
NEW YORK, Jan. 19, 2022 /PRNewswire-PRWeb/ -- After a year of unprecedented ransomware attacks on hospitals and healthcare systems – and with healthcare now the…
Read More
